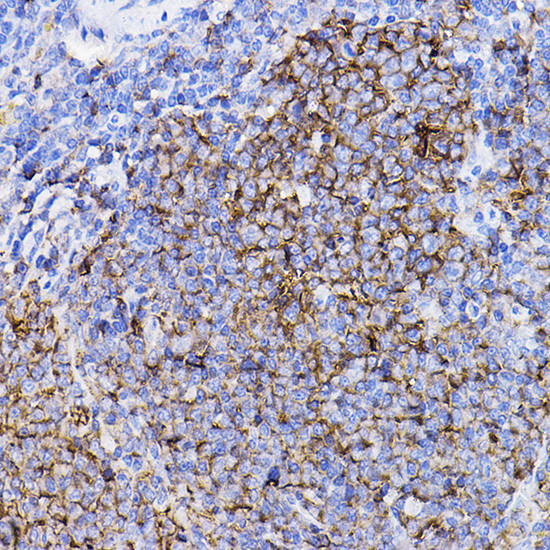
TGFBR2 Antibody in Immunohistochemistry (Paraffin) (IHC (P))

Search
Invitrogen
TGFBR2 Polyclonal Antibody
{{$productOrderCtrl.translations['antibody.pdp.commerceCard.promotion.promotions']}}
{{$productOrderCtrl.translations['antibody.pdp.commerceCard.promotion.viewpromo']}}
{{$productOrderCtrl.translations['antibody.pdp.commerceCard.promotion.promocode']}}: {{promo.promoCode}} {{promo.promoTitle}} {{promo.promoDescription}}. {{$productOrderCtrl.translations['antibody.pdp.commerceCard.promotion.learnmore']}}
图: 1 / 3
TGFBR2 Antibody (PA5-88257) in IHC (P)



Please note: We are reviewing Western blot images included in the antibody testing data in our catalog, including those provided by third parties. Unless expressly labeled or annotated as “raw-unedited”, Western blot images included in the antibody testing data in our catalog may have been edited, optimized or otherwise adjusted for presentation.
产品信息
PA5-88257
种属反应
已发表种属
宿主/亚型
分类
类型
抗原
偶联物
形式
浓度
规格
纯化类型
保存液
内含物
保存条件
运输条件
RRID
产品详细信息
Positive Samples: Mouse spleen, Rat lung; Cellular Location: Cell membrane, Single-pass type I membrane protein
靶标信息
Transforming Growth Factor, beta receptor 2 (AAT3, FAA3, MFS2, RIIC, LDS1B, LDS2B, TAAD2, TGFR-2, TGFbeta-RII) is a member of the TGF-beta family of receptor Serine/Threonine kinases. It is involved in the regulation of cell proliferation. Mitochondrial ATP synthase catalyzes ATP synthesis, utilizing an electrochemical gradient of protons across the inner membrane during oxidative phosphorylation. ATP synthase is composed of two linked multi-subunit complexes: the soluble catalytic core, F1, and the membrane-spanning component, Fo, comprising the proton channel. The catalytic portion of mitochondrial ATP synthase consists of 5 different subunits (alpha, beta, gamma, delta, and epsilon) assembled with a stoichiometry of 3 alpha, 3 beta, and a single representative of the other 3. The proton channel consists of three main subunits (a, b, c). TGFBR2 encodes the gamma subunit of the catalytic core. Alternatively spliced transcript variants encoding different isoforms have been identified. TGFBR2 also has a pseudogene on chromosome 14.
仅用于科研。不用于诊断过程。未经明确授权不得转售。
生物信息学
蛋白别名: tbetaR-II; tgf beta receptor 2; TGF-beta receptor II; TGF-beta receptor type II; TGF-beta receptor type-2; TGF-beta type II receptor; TGFbeta RII; TGFR-2; TGFR2; transforming growth factor beta receptor type II; transforming growth factor, beta receptor II; transforming growth factor, beta receptor IIT; transforming growth factor-b type II receptor; Transforming growth factor-beta receptor type II; transforming growth factor-beta type II receptor
基因别名: 1110020H15Rik; AU042018; DNIIR; RIIDN; TbetaR-II; TbetaRII; TBR-II; TGF-beta 2; Tgfbr2; Tgfbr2T
UniProt ID: (Rat) P38438, (Mouse) Q62312
Entrez Gene ID: (Rat) 81810, (Mouse) 21813